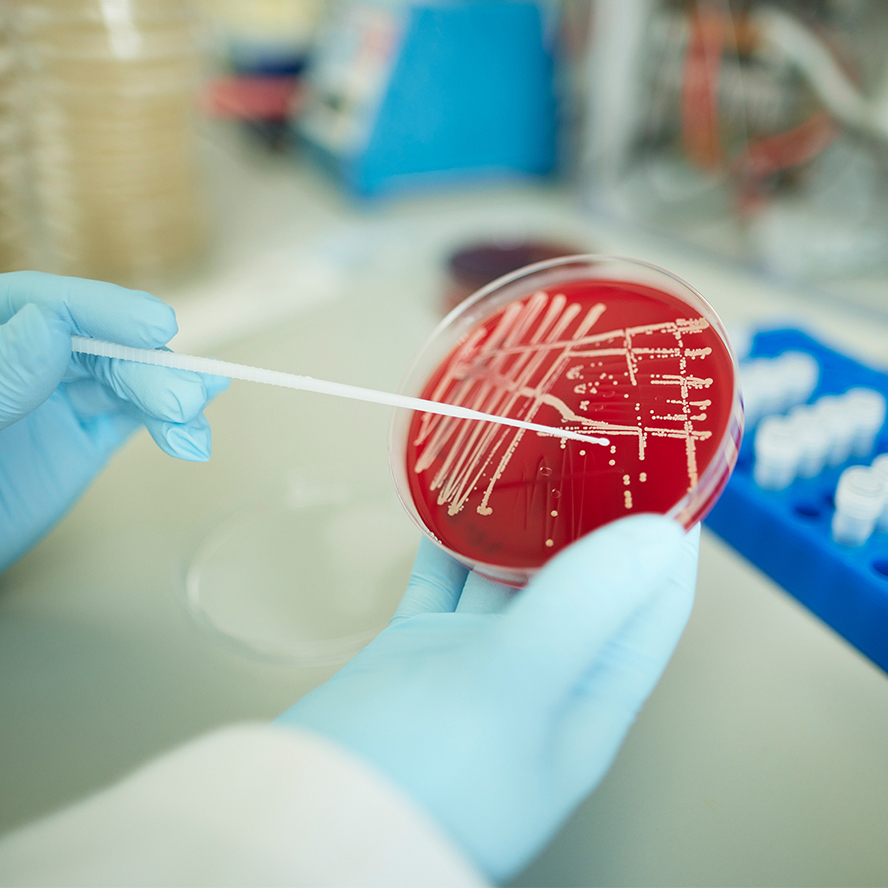

Infection
Vision & mission
The potential impact of infectious diseases on individuals, societies, and our planet needs no further introduction. Preparedness, prevention, and medical interventions depend on our detailed understanding of the biology and evolution of pathogens, their interactions with the host and its immune system, and the diseases they can cause. Theme Infection aims to deliver knowledge-driven prevention strategies and cures, for the infectious diseases of today and tomorrow.
…The potential impact of infectious diseases on individuals, societies, and our planet needs no further introduction. Preparedness, prevention, and medical interventions depend on our detailed understanding of the biology and evolution of pathogens, their interactions with the host and its immune system, and the diseases they can cause. Theme Infection aims to deliver knowledge-driven prevention strategies and cures, for the infectious diseases of today and tomorrow.
Translating knowledge into solutions
LUMC Theme Infection supports, inspires, and unites researchers working in the field of infection in LUMC and beyond. Our Theme is built on a strong community of biomedical scientists and clinicians, who dissect host-pathogen interactions to develop out-of-the-box prevention strategies and cures for the most pressing infectious disease challenges.
Our vision
LUMC Theme Infection aims to be an inspirational leader in the development of knowledge-driven strategies to combat infectious diseases through the development of novel diagnostics, epidemiological models, vaccines, drugs, and immune modulators.
The impact of infections
Given the steady influx of emerging infectious agents, increasing drug resistance, and the reduced efficacy of some new key vaccines in low- and middle-income countries, strong and effective research and preparedness programs are needed to face the challenges that lie ahead.
Special consideration is given to vulnerable populations, such as children, the elderly, and immunocompromised persons.
The recent COVID-19 pandemic has highlighted the threatening power and speed of globally emerging infectious agents, underlining the importance of effective preparedness and vaccination programs.
About us
Simon Jochems
 Simon Jochems leads a research group at the Leiden University Center for Infectious Diseases. His research is focused on understanding how the immune system protects against respiratory infections and how it responds to vaccines. He specifically studies the sites where immunity develops (lymph nodes) and where these infections first occur: in the upper airways. Using minimally invasive sampling methods, his team studies immune cells in these tissues after vaccination or while infected with bacteria and viruses such as SARS-CoV-2 and influenza.
Simon Jochems leads a research group at the Leiden University Center for Infectious Diseases. His research is focused on understanding how the immune system protects against respiratory infections and how it responds to vaccines. He specifically studies the sites where immunity develops (lymph nodes) and where these infections first occur: in the upper airways. Using minimally invasive sampling methods, his team studies immune cells in these tissues after vaccination or while infected with bacteria and viruses such as SARS-CoV-2 and influenza.
Click here for profile Simon Jochems
Jutte de Vries

Jutte de Vries is an Associate Professor in Clinical Virology at the Leiden University Center for Infectious Diseases (LUCID). She leads a research group focusing on Clinical Viral Metagenomics and related fields, including viral genomics, intra-host evolution, virus–host transcriptomics, and virus discovery, contributing to Epidemic and Pandemic Preparedness. Her team’s mission is to improve pathogen identification and characterization through innovative metagenomic sequencing methods to benefit clinical care and strengthen public health surveillance, with the goal of fostering globally resilient health systems.
Click here for profile Jutte de Vries
Willianne Hoepel
 Willianne Hoepel is a starting group leader at the Department of Immunology. She studies antibody glycosylation in context of respiratory viral infections. Her
Willianne Hoepel is a starting group leader at the Department of Immunology. She studies antibody glycosylation in context of respiratory viral infections. Her
research is supported by a VENI grant of the Netherlands Organization for Scientific Research (NWO) and the
Young Investigators Grant of the Dutch Lung Foundation. Besides she is also a member of the Young Investigator Board of the NRS (Netherlands Respiratory Society). She is also supervising master and PhD students and is involved in teaching during Half Minor program and FOS courses at the LUMC.
Subthemes
Collaborations
In addition to LUMC departments, Theme Infection has strong connections with other faculties of Leiden University, the Leiden Bioscience Park, and beyond. Like:
- Collaboration with University of Edinburgh – Related to One Health projects
- Collaborations with field sites in Bangladesh, Brazil, Gabon, Indonesia, Uganda, South-Africa and more
- Strong link to centers in low middle income countries
Opportunities
Contact
Email:Infection@lumc.nl
&width=888)
&width=593)